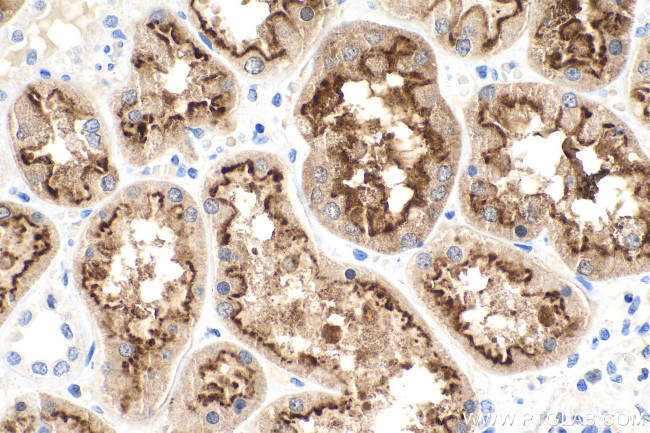
LRP2 Antibody in Immunohistochemistry (Paraffin) (IHC (P))

Search
Proteintech
LRP2 Polyclonal Antibody
{{$productOrderCtrl.translations['antibody.pdp.commerceCard.promotion.promotions']}}
{{$productOrderCtrl.translations['antibody.pdp.commerceCard.promotion.viewpromo']}}
{{$productOrderCtrl.translations['antibody.pdp.commerceCard.promotion.promocode']}}: {{promo.promoCode}} {{promo.promoTitle}} {{promo.promoDescription}}. {{$productOrderCtrl.translations['antibody.pdp.commerceCard.promotion.learnmore']}}
产品信息
19700-1-AP
种属反应
已发表种属
宿主/亚型
分类
类型
抗原
偶联物
形式
浓度
规格
纯化类型
保存液
内含物
保存条件
运输条件
产品详细信息
This antibody is specific to LRP2 and detects endogenous LRP2 with an apparent molecular weight 280 kDa, which is smaller than the predicted molecular weight (522 kDa) and probably represent a proteolytic fragment of the large glycoprotein.
靶标信息
The protein encoded by this gene, low density lipoprotein-related protein 2 (LRP2) or megalin, is a multi-ligand endocytic receptor that is expressed in many different tissues but primarily in absorptive epithilial tissues such as the kidney. This glycoprotein has a large amino-terminal extracellular domain, a single transmembrane domain, and a short carboxy-terminal cytoplasmic tail. The extracellular ligand-binding-domains bind diverse macromolecules including albumin, apolipoproteins B and E, and lipoprotein lipase. The LRP2 protein is critical for the reuptake of numerous ligands, including lipoproteins, sterols, vitamin-binding proteins, and hormones. This protein also has a role in cell-signaling; extracellular ligands include parathyroid horomones and the morphogen sonic hedgehog while cytosolic ligands include MAP kinase scaffold proteins and JNK interacting proteins. Recycling of this membrane receptor is regulated by phosphorylation of its cytoplasmic domain. Mutations in this gene cause Donnai-Barrow syndrome (DBS) and facio-oculoacoustico-renal syndrome (FOAR).
仅用于科研。不用于诊断过程。未经明确授权不得转售。
生物信息学
蛋白别名: calcium sensor protein; Glycoprotein 330; gp330; Heymann nephritis antigen homolog; Low-density lipoprotein receptor-related protein 2; LRP-2; Megalin; transmembrane receptor; unnamed protein product
基因别名: DBS; GP330; LRP-2; LRP2
UniProt ID: (Human) P98164
Entrez Gene ID: (Human) 4036